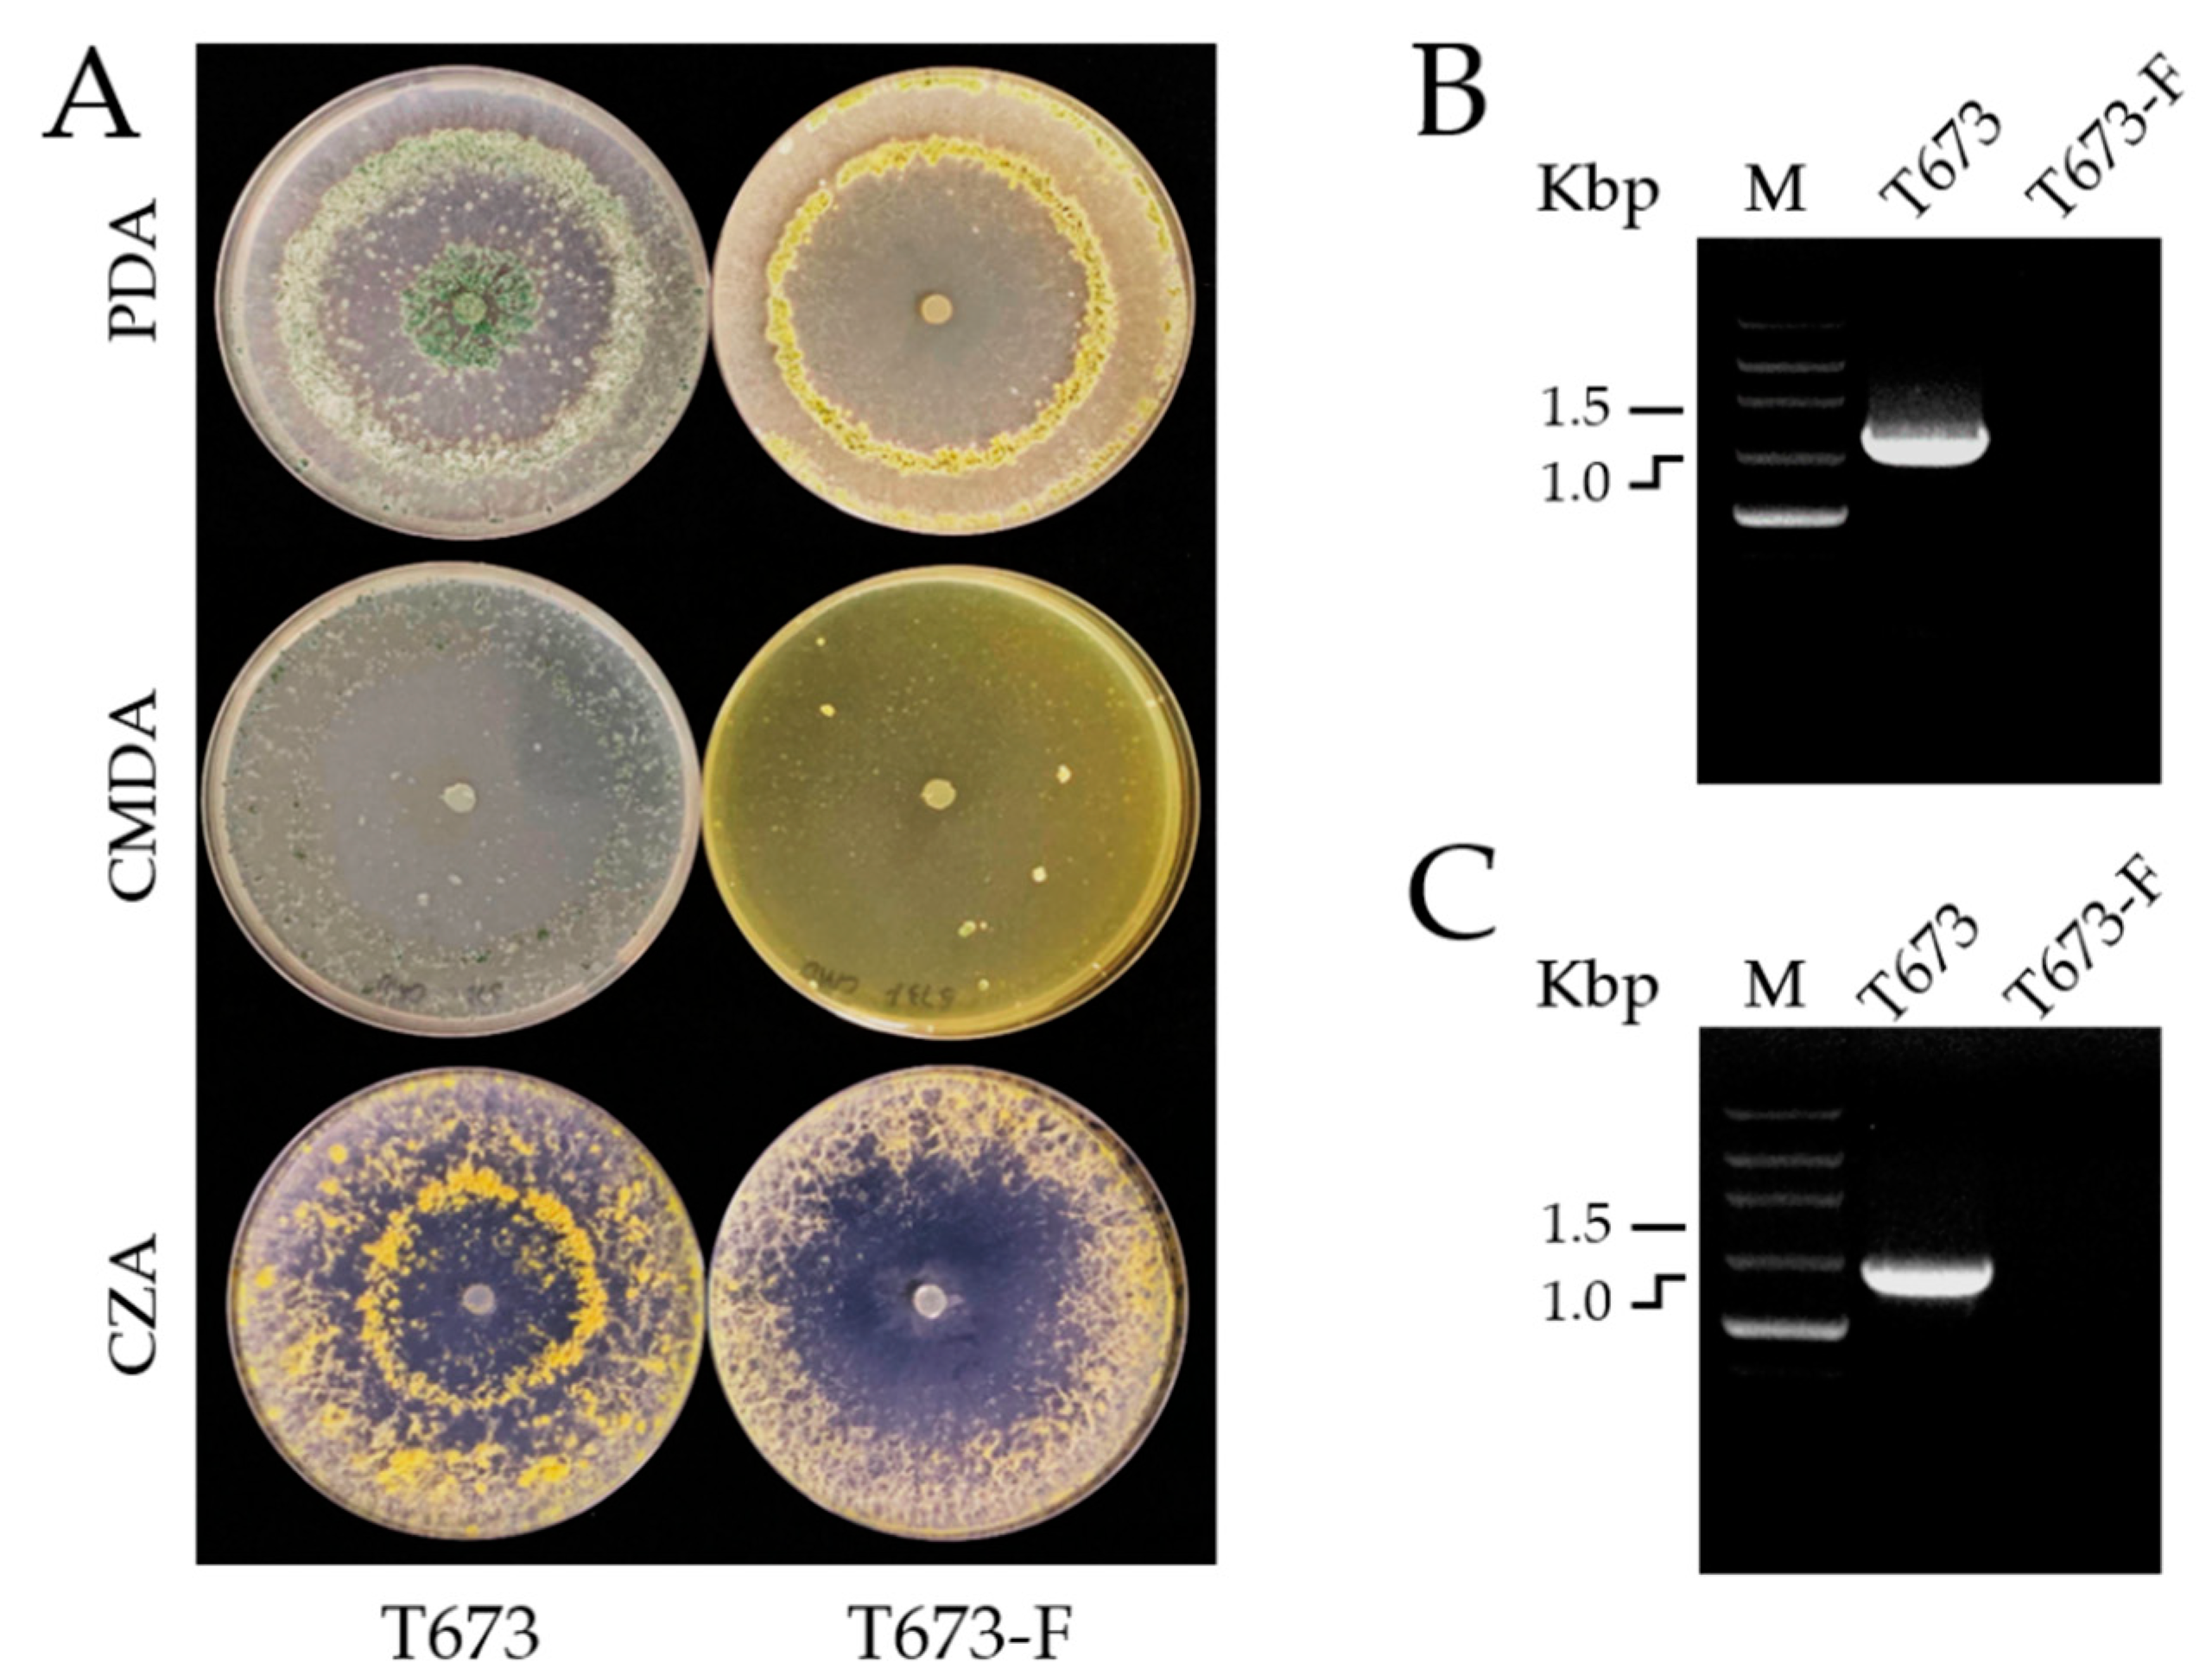
Viruses 14 01532 g003 Viruses 14 01532 g003

The Newly Identified Trichoderma harzianum Partitivirus (ThPV2) Does Not Diminish Spore Production and Biocontrol Activity of Its Host
Abstract
1. Background
2. Methods
2.1. Extraction and Purification of dsRNA
2.2. RNA Sequencing
2.3. Characterization of the Mycovirus Genome
2.4. Phylogenetic Analysis
2.5. Mycovirus Elimination from Isolate T673
2.6. Effects of Mycovirus Infection on the Antagonistic Activity of T. harzianum In Vitro
2.7. Effects of Mycovirus Infection on the Biological Characteristics of T. harzianum
2.7.1. Colony Morphology and Biomass
2.7.2. Conidiospore and Chlamydospore Production
2.7.3. Plant Growth Promotion and Biocontrol Activity
3. Results
3.1. Characterization of the dsRNA Mycovirus Genome
3.2. Organization of the T673-Derived Mycoviral Genome
3.3. Phylogenetic Analysis and Taxonomy of Trichoderma harzianum Partitivirus 2 (ThPV2)
3.4. Biological Effects of ThPV2 on Trichoderma harzianum T673
3.4.1. Generation of a Cured Strain
3.4.2. Effects of ThPV2 Infection on Morphology and Growth of Trichoderma
3.4.3. Effect of ThPV2 Infection on Spore Production of T. harzianum
3.4.4. Effect of ThPV2 Infection on Trichoderma-Triggered Plant Development
3.4.5. Effect of ThPV2 Infection on Trichoderma Antagonistic and Biocontrol Potential
4. Discussion
Supplementary Materials
Author Contributions
Funding
Institutional Review Board Statement
Informed Consent Statement
Data Availability Statement
Acknowledgments
Conflicts of Interest
References
- Hollings, M. Viruses associated with a die-back disease of cultivated mushroom. Nature 1962, 196, 962–965. [Google Scholar] [CrossRef]
- Buck, K.W. Fungal virology—An overview. In Fungal Virology; CRC Press: Boca Raton, FL, USA, 1986; pp. 1–84. [Google Scholar] [CrossRef]
- Turina, M.; Rostagno, L. Virus-induced hypovirulence in Cryphonectria parasitica: Still an unresolved conundrum. J. Plant Pathol. 2007, 89, 165–178. [Google Scholar] [CrossRef]
- Biella, S.; Smith, M.L.; Cortesi, P.; Milgroom, M.G. Programmed cell death correlates with virus transmission in a filamentous fungus. Proc. R. Soc. B Biol. Sci. 2002, 269, 2269–2276. [Google Scholar] [CrossRef]
- Ghabrial, S.A.; Suzuki, N. Viruses of plant pathogenic fungi. Annu. Rev. Phytopathol. 2009, 47, 353–384. [Google Scholar] [CrossRef] [PubMed]
- Juárez-Hernández, E.O.; Casados-Vázquez, L.E.; Bideshi, D.K.; Salcedo-Hernández, R.; Barboza-Corona, J.E. Role of the C-terminal and chitin insertion domains on enzymatic activity of endochitinase ChiA74 of Bacillus thuringiensis. Int. J. Biol. Macromol. 2017, 102, 52–59. [Google Scholar] [CrossRef] [PubMed]
- Cai, F.; Druzhinina, I.S. In honor of John Bissett: Authoritative guidelines on molecular identification of Trichoderma. Fungal Divers. 2021, 107, 1–69. [Google Scholar] [CrossRef]
- Weindling, R. Trichoderma lignorum as a parasite of other fungi. Phytopathology 1932, 22, 837–845. [Google Scholar] [CrossRef]
- Nawrock, A.J.; Malolepsza, U. Diversity in plant systemic resistance induced by Trichoderma. Biol. Control 2013, 67, 149–156. [Google Scholar] [CrossRef]
- Harman, G.E.; Howell, C.R.; Viterbo, A.; Chet, I.; Lorito, M. Trichoderma species–opportunistic, avirulent plant symbionts. Nat. Rev. Microbiol. 2004, 2, 43–56. [Google Scholar] [CrossRef]
- Tucci, M.; Ruocco, M.; De Masi, L.; De Palma, M.; Lorito, M. The beneficial effect of Trichoderma spp. on tomato is modulated by the plant genotype. Mol. Plant Pathol. 2011, 12, 341–354. [Google Scholar] [CrossRef]
- Wu, B.L.; Li, M.; Liu, C.; Jiang, X. The insight of mycovirus from Trichoderma spp. Agric. Res. Technol. Open Access J. 2020, 24, 556258. [Google Scholar] [CrossRef]
- Jom-in, S.; Akarapisan, A. Characterization of double-stranded RNA in Trichoderma spp. isolates in Chiang Mai province. J. Agric. Technol. 2009, 5, 261–270. [Google Scholar]
- Yun, S.H.; Lee, S.H.; So, K.K.; Kim, J.M.; Kim, D.H. Incidence of diverse dsRNA mycoviruses in Trichoderma spp. causing green mold disease of shiitake Lentinula edodes. FEMS Microbiol. Lett. 2016, 363, fnw220. [Google Scholar] [CrossRef] [PubMed]
- Lee, S.H.; Yun, S.H.; Chun, J.; Kim, D.H. Characterization of a novel dsRNA mycovirus of Trichoderma atroviride NFCF028. Arch. Virol. 2017, 162, 1073–1077. [Google Scholar] [CrossRef]
- Chun, J.; Yang, H.E.; Kim, D.H. Identification and molecular characterization of a novel partitivirus from Trichoderma atroviride NFCF394. Viruses 2018, 10, 578. [Google Scholar] [CrossRef]
- Chun, J.; Yang, H.E.; Kim, D.H. Identification of a novel partitivirus of Trichoderma harzianum NFCF319 and evidence for the related antifungal activity. Front. Plant Sci. 2018, 9, 1699. [Google Scholar] [CrossRef] [PubMed]
- Zhang, T.; Zeng, X.; Cai, X.; Liu, H.; Zeng, Z. Molecular characterization of a novel double-stranded RNA mycovirus of Trichoderma asperellum strain JLM45-3. Arch. Virol. 2018, 163, 3433–3437. [Google Scholar] [CrossRef]
- Liu, C.C.; Li, M.; Redda, E.T.; Mei, J.; Zhang, J.; Elena, S.F.; Wu, B.L.; Jiang, X.L. Complete nucleotide sequence of a novel mycovirus from Trichoderma harzianum in China. Arch. Virol. 2019, 164, 1213–1216. [Google Scholar] [CrossRef]
- Liu, C.C.; Li, M.; Redda, E.T.; Mei, J.; Zhang, J.; Wu, B.L.; Jiang, X.L. A novel double-stranded RNA mycovirus isolated from Trichoderma harzianum. Virol. J. 2019, 16, 113. [Google Scholar] [CrossRef]
- You, J.; Zhou, K.; Liu, X.; Wu, M.; Yang, L.; Zhang, J.; Chen, W.; Li, G. Defective RNA of a novel mycovirus with high transmissibility detrimental to biocontrol properties of Trichoderma spp. Microorganisms 2019, 7, 507. [Google Scholar] [CrossRef]
- Chun, J.; So, K.; Ko, Y.H.; Kim, D.H. Molecular characteristics of a novel hypovirus from Trichoderma harzianum. Arch. Virol. 2021, 167, 233–238. [Google Scholar] [CrossRef] [PubMed]
- DePaulo, J.; Powell, C. Extraction of double-stranded RNA from plant tissues without the use of organic solvents. Plant Dis. 1995, 79, 246–248. [Google Scholar] [CrossRef]
- Potgieter, A.C.; Page, N.A.; Liebenberg, J.; Wright, I.M.; Landt, O.; VanDijk, A.A. Improved strategies for sequence-independent amplification and sequencing of viral double-stranded RNA genomes. J. Gen. Virol. 2009, 90, 1423–1432. [Google Scholar] [CrossRef] [PubMed]
- Hou, Z.; Xue, C.; Peng, Y.; Katan, T.; Kistler, H.C.; Xu, J.R. A mitogen-activated protein kinase gene (MGV1) in Fusarium graminearum is required for female fertility, heterokaryon formation, and plant infection. Mol. Plant Microbe Interact. 2002, 15, 1119–1127. [Google Scholar] [CrossRef]
- Wang, Y.; Liu, S.; Zhu, H.J.; Zhong, J. Molecular characterization of a novel mycovirus from the plant pathogenic fungus Colletotrichum gloeosporioides. Arch. Virol. 2019, 164, 2859–2863. [Google Scholar] [CrossRef]
- Stothard, P. The Sequence Manipulation Suite: JavaScript programs for analyzing and formatting protein and DNA sequences. Biotechniques 2000, 28, 1102–1104. [Google Scholar] [CrossRef] [PubMed]
- Altschul, S.F.; Gish, W.; Miller, W.; Myers, E.W.; Lipman, D.J. Basic local alignment search tool. J. Mol. Biol. 1990, 215, 403–410. [Google Scholar] [CrossRef]
- Kumar, S.; Stecher, G.; Tamura, K. MEGA7, molecular evolutionary genetics analysis version 7.0 for bigger datasets. Mol. Biol. Evol. 2016, 33, 1870–1874. [Google Scholar] [CrossRef]
- Fisher-Box, J. Guinness, Gosset, Fisher, and Small Samples. Stat. Sci. 1987, 2, 45–52. [Google Scholar]
- Chiapello, M.; Rodriguez-Romero, J.; Ayllón, M.A.; Turina, M. Analysis of the virome associated to grapevine downy mildew lesions reveals new mycovirus lineages. Virus Evol. 2020, 6, veaa058. [Google Scholar] [CrossRef]
- Zheng, F.; Xu, G.; Zhou, J.; Xie, C.; Cui, H.; Miao, W.; Kang, Z.; Zheng, L. Complete genomic sequence and organization of a novel mycovirus from Phoma matteuccicola strain LG915. Arch. Virol. 2019, 164, 2209–2213. [Google Scholar] [CrossRef] [PubMed]
- Zhong, J.; Zhu, J.Z.; Lei, X.H.; Chen, D.; Zhu, H.J.; Gao, B.D. Complete genome sequence and organization of a novel virus from the rice false smut fungus Ustilaginoide avirens. Virus Genes 2014, 48, 329–333. [Google Scholar] [CrossRef] [PubMed]
- Vainio, E.J.; Chiba, S.; Ghabrial, S.A.; Maiss, E.; Roossinck, M.; Sabanadzovic, S.; Suzuki, N.; Xie, J.; Nibert, M. ICTV Report consortium. ICTV virus taxonomy Profile: Partitiviridae. Gen. Virol. 2018, 99, 17–18. [Google Scholar] [CrossRef] [PubMed]
- Velasco, L.; López-Herrera, C.; Cretazzo, E. Two novel partitiviruses that accumulate differentially in Rosellinia necatrix and Entoleuca sp. infecting avocado. Virus Res. 2020, 285, 198020. [Google Scholar] [CrossRef]
- Kim, J.W.; Choi, E.Y.; Kim, Y.T. Intergeneric relationship between the Aspergillus ochraceous virus F and the Penicillium stoloniferum virus S. Virus Res. 2006, 120, 212–215. [Google Scholar] [CrossRef] [PubMed]
- Nerva, L.; Forgia, M.; Ciuffo, M.; Chitarra, W.; Chiapello, M.; Vallino, M.; Varese, G.C.; Turina, M. The mycovirome of a fungal collection from the sea cucumber Holothuriapolii. Virus Res. 2019, 273, 197737. [Google Scholar] [CrossRef]
- Nemchinov, L.G.; Lee, M.N.; Shao, J. First report of alphapartitiviruses infecting alfalfa (Medicago sativa L.) in the United States. Microbiol. Resour. Announc. 2018, 7, e01266-18. [Google Scholar] [CrossRef]
- Osaki, H.; Sasaki, A.; Nomiyama, K.; Tomioka, K. Multiple virus infection in a single strain of Fusarium poae shown by deep sequencing. Virus Genes 2016, 52, 835–847. [Google Scholar] [CrossRef]
- Chiba, S.; Lin, Y.H.; Kondo, H.; Kanematsu, S.; Suzuki, N. A novel betapartitivirus RnPV6 from Rosellinia necatrix tolerates host RNA silencing but is interfered by its defective RNAs. Virus Res. 2016, 219, 62–72. [Google Scholar] [CrossRef]
- Elbeaino, T.; Kubaa, R.A.; Digiaro, M.; Minafra, A.; Martelli, G.P. The complete nucleotide sequence and genome organization of fig cryptic virus, a novel bipartite dsRNA virus infecting fig, widely distributed in the Mediterranean basin. Virus Genes 2011, 42, 415–421. [Google Scholar] [CrossRef]
- Sabanadzovic, S.; Valverde, R.A. Properties and detection of two cryptoviruses from pepper (Capsicum annuum). Virus Genes 2011, 43, 307–312. [Google Scholar] [CrossRef] [PubMed]
- Vong, M.; Ludington, J.G.; Ward, H.D.; Nibert, M.L. Complete cryspovirus genome sequences from Cryptosporidium parvum isolate Iowa. Arch. Virol. 2017, 162, 2875–2879. [Google Scholar] [CrossRef] [PubMed]
- Zhong, J.; Lei, X.H.; Zhu, J.Z.; Song, G.; Zhang, Y.D.; Chen, Y.; Gao, B.D. Detection and sequence analysis of two novel co-infecting double-strand RNA mycoviruses in Ustilaginoidea virens. Arch. Virol. 2014, 159, 3063–3070. [Google Scholar] [CrossRef] [PubMed]
- Oliveira-Garcia, E.; Tiedemann, A.V.; Deising, H.B. The measure mix matters: Multiple-component plant protection is indispensable for coping with the enormous genome plasticity and mutation rates in pathogenic microorganisms. J. Plant Dis. Prot. 2021, 128, 3–6. [Google Scholar] [CrossRef]
- Sharma, A.; Kumar, V.; Shahzad, B.; Tanveer, M.; Sidhu, G.P.S.; Handa, N.; Kohli, S.K.; Yadav, P.; Bali, A.S.; Parihar, R.D.; et al. Worldwide pesticide usage and its impacts on ecosystem. SN Appl. Sci. 2019, 1, 1446. [Google Scholar] [CrossRef]
- Woo, S.L.; Ruocco, M.; Vinale, F.; Nigro, M.; Marra, R.; Lombardi, N.; Pascale, A.; Lanzuise, S.; Manganiello, G.; Lorito, M. Trichoderma-based products and their widespread use in agriculture. Open Mycol. J. 2014, 8, 71–126. [Google Scholar] [CrossRef]
- Oerke, E.C. Crop losses to pests. J. Agric. Sci. 2006, 144, 31–43. [Google Scholar] [CrossRef]
- Deising, H.B.; Gase, I.; Kubo, Y. The unpredictable risk imposed by microbial secondary metabolites: How safe is biological control of plant diseases? J. Plant Dis. Protect. 2017, 124, 413–419. [Google Scholar] [CrossRef]
- Rush, T.A.; Shrestha, H.K.; Meena, M.G.; Spangler, M.K.; Ellis, C.; Labbé, J.L.; Abraham, P.E. Bioprospecting Trichoderma: A systematic roadmap to screen genomes and natural products for biocontrol applications. Front. Fungal Biol. 2021, 2, 716511. [Google Scholar] [CrossRef]
- Brožová, J. Mycoparasitic fungi Trichoderma spp. in plant protection. Plant Prot. Sci. 2004, 40, 63–74. [Google Scholar] [CrossRef]
- Zin, N.A.; Badaluddin, N.A. Biological functions of Trichoderma spp. for agriculture applications. Ann. Agric. Sci. 2020, 65, 168–178. [Google Scholar] [CrossRef]
- Heiniger, U.; Rigling, D. Biological control of chestnut blight in Europe. Annu. Rev. Phytopathol. 1994, 32, 581–599. [Google Scholar] [CrossRef]
- Dawe, A.L.; Nuss, D.L. Hypovirus and chestnut blight: Exploiting viruses to understand and modulate fungal pathogenesis. Annu. Rev. Genet. 2001, 35, 1–29. [Google Scholar] [CrossRef]
- Chu, Y.M.; Jeon, J.J.; Yea, S.J.; Kim, Y.H.; Yun, S.H.; Lee, Y.W.; Kim, K.H. Double-stranded RNA mycovirus from Fusarium graminearum. Appl. Environ. Microbiol. 2002, 68, 2529–2534. [Google Scholar] [CrossRef] [PubMed]
- Yu, X.; Li, B.; Fu, Y. Extracellular transmission of a DNA mycovirus and its use as a natural fungicide. Proc. Natl. Acad. Sci. USA 2013, 110, 1452–1457. [Google Scholar] [CrossRef] [PubMed]
- Pearson, M.N.; Bailey, A.M. Viruses of Botrytis. Adv. Virus Res. 2013, 86, 249–272. [Google Scholar] [CrossRef]
- Wu, M.D.; Zhang, L.; Li, G.; Jiang, D.; Ghabrial, S.A. Genome characterization of a debilitation-associated mitovirus infecting the phytopathogenic fungus Botrytis cinerea. Virology 2010, 406, 117–126. [Google Scholar] [CrossRef]
- Yaegashi, H.; Kanematsu, S.; Ito, T. Molecular characterization of a new hypovirus infecting a phytopathogenic fungus, Valsa ceratosperma. Virus Res. 2012, 165, 143–150. [Google Scholar] [CrossRef]
- Wang, R.Q.; Liu, C.C.; Tan, Z.Y.; Shang, Q.X.; Wu, B.L.; Jiang, X.L. The exploration of mycoviruses from Trichoderma spp. Agric. Res. Technol. Open Access J. 2021, 25, 556310. [Google Scholar] [CrossRef]

Publisher’s Note: MDPI stays neutral with regard to jurisdictional claims in published maps and institutional affiliations. |
© 2022 by the authors. Licensee MDPI, Basel, Switzerland. This article is an open access article distributed under the terms and conditions of the Creative Commons Attribution (CC BY) license (https://creativecommons.org/licenses/by/4.0/).
Share and Cite
Wang, R.; Liu, C.; Jiang, X.; Tan, Z.; Li, H.; Xu, S.; Zhang, S.; Shang, Q.; Deising, H.B.; Behrens, S.-E.; et al. The Newly Identified Trichoderma harzianum Partitivirus (ThPV2) Does Not Diminish Spore Production and Biocontrol Activity of Its Host. Viruses 2022, 14, 1532. https://doi.org/10.3390/v14071532
Wang R, Liu C, Jiang X, Tan Z, Li H, Xu S, Zhang S, Shang Q, Deising HB, Behrens S-E, et al. The Newly Identified Trichoderma harzianum Partitivirus (ThPV2) Does Not Diminish Spore Production and Biocontrol Activity of Its Host. Viruses. 2022; 14(7):1532. https://doi.org/10.3390/v14071532
Chicago/Turabian StyleWang, Rongqun, Chenchen Liu, Xiliang Jiang, Zhaoyan Tan, Hongrui Li, Shujin Xu, Shuaihu Zhang, Qiaoxia Shang, Holger B. Deising, Sven-Erik Behrens, and et al. 2022. "The Newly Identified Trichoderma harzianum Partitivirus (ThPV2) Does Not Diminish Spore Production and Biocontrol Activity of Its Host" Viruses 14, no. 7: 1532. https://doi.org/10.3390/v14071532
APA StyleWang, R., Liu, C., Jiang, X., Tan, Z., Li, H., Xu, S., Zhang, S., Shang, Q., Deising, H. B., Behrens, S.-E., & Wu, B. (2022). The Newly Identified Trichoderma harzianum Partitivirus (ThPV2) Does Not Diminish Spore Production and Biocontrol Activity of Its Host. Viruses, 14(7), 1532. https://doi.org/10.3390/v14071532

